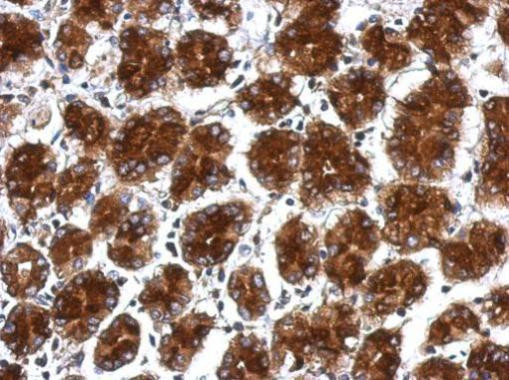
RPLP0 Antibody in Immunohistochemistry (Paraffin) (IHC (P))

Search
Invitrogen
RPLP0 Polyclonal Antibody
{{$productOrderCtrl.translations['antibody.pdp.commerceCard.promotion.promotions']}}
{{$productOrderCtrl.translations['antibody.pdp.commerceCard.promotion.viewpromo']}}
{{$productOrderCtrl.translations['antibody.pdp.commerceCard.promotion.promocode']}}: {{promo.promoCode}} {{promo.promoTitle}} {{promo.promoDescription}}. {{$productOrderCtrl.translations['antibody.pdp.commerceCard.promotion.learnmore']}}





Please note: We are reviewing Western blot images included in the antibody testing data in our catalog, including those provided by third parties. Unless expressly labeled or annotated as “raw-unedited”, Western blot images included in the antibody testing data in our catalog may have been edited, optimized or otherwise adjusted for presentation.
产品信息
PA5-30158
种属反应
宿主/亚型
分类
类型
抗原
偶联物
形式
浓度
规格
纯化类型
保存液
保存条件
运输条件
RRID
产品详细信息
Recommended positive controls: 293T, A431.
Predicted reactivity: Mouse (96%), Rat (96%), Zebrafish (87%), Xenopus laevis (91%), Dog (99%), Chicken (96%), Rhesus Monkey (99%), Bovine (97%).
Store product as a concentrated solution. Centrifuge briefly prior to opening the vial.
靶标信息
Ribosomes, the organelles that catalyze protein synthesis, consist of a small 40S subunit and a large 60S subunit. Together these subunits are composed of 4 RNA species and approximately 80 structurally distinct proteins. This gene encodes a ribosomal protein that is a component of the 60S subunit. The protein, which is the functional equivalent of the E. coli L10 ribosomal protein, belongs to the L10P family of ribosomal proteins. It is a neutral phosphoprotein with a C-terminal end that is nearly identical to the C-terminal ends of the acidic ribosomal phosphoproteins P1 and P2. The P0 protein can interact with P1 and P2 to form a pentameric complex consisting of P1 and P2 dimers, and a P0 monomer. The protein is located in the cytoplasm. Transcript variants derived from alternative splicing exist; they encode the same protein. As is typical for genes encoding ribosomal proteins, there are multiple processed pseudogenes of this gene dispersed through the genome.
仅用于科研。不用于诊断过程。未经明确授权不得转售。
篇参考文献 (0)
生物信息学
蛋白别名: 60S acidic ribosomal protein P0; 60S ribosomal protein L10E; Large ribosomal subunit protein uL10; MGC107165; MGC107166; MGC111226; MGC88175; OTTMUSP00000015585; rplRP
基因别名: RPLP0
Entrez Gene ID: (Human) 6175